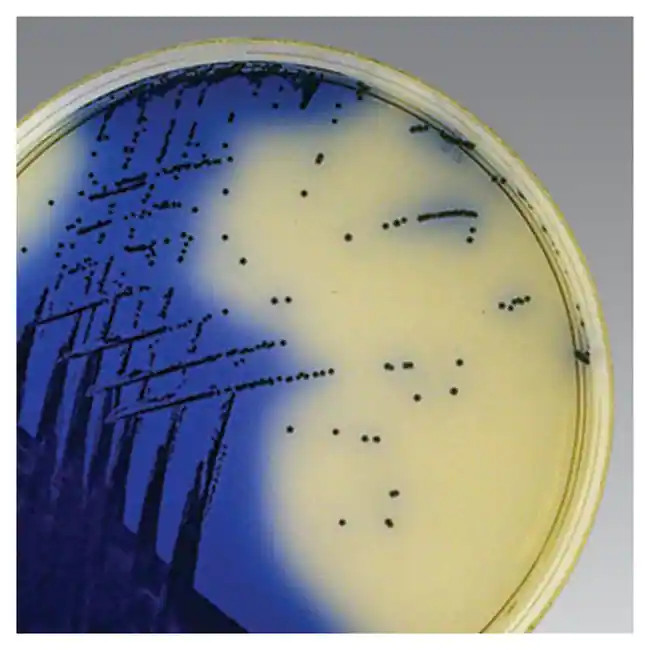
Thermo Scientific™ Oxoid™ ORSAB Selective Supplement

Description
Description
Oxoid ORSAB Selective Supplement (Oxacillin Resistance Screening Agar Base Selective Supplement) is added to Oxacillin Resistance Screening Agar Base, Part No. CM1008B.
Add to Oxacillin Resistance Screening Agar Base, Part No. CM1008B
Each vial supplements 500mL of medium
Specifications
Description
ORSAB Selective Supplement
Product Type
Selective Supplement
Quantity
10/Pk.
Format
Freeze Dried
Type
Supplement
Yield
Each vial for 500mL medium